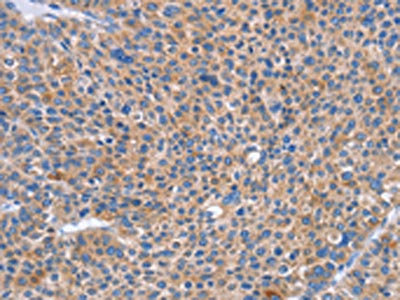

SIGLEC7 Antibody
-
中文名稱:SIGLEC7兔多克隆抗體
-
貨號(hào):CSB-PA803018
-
規(guī)格:¥1100
-
圖片:
-
The image on the left is immunohistochemistry of paraffin-embedded Human liver cancer tissue using CSB-PA803018(SIGLEC7 Antibody) at dilution 1/50, on the right is treated with synthetic peptide. (Original magnification: ×200)
-
The image on the left is immunohistochemistry of paraffin-embedded Human thyroid cancer tissue using CSB-PA803018(SIGLEC7 Antibody) at dilution 1/50, on the right is treated with synthetic peptide. (Original magnification: ×200)
-
Gel: 8%SDS-PAGE, Lysate: 40 μg, Lane: A549 cells, Primary antibody: CSB-PA803018(SIGLEC7 Antibody) at dilution 1/650, Secondary antibody: Goat anti rabbit IgG at 1/8000 dilution, Exposure time: 20 seconds
-
-
其他:
產(chǎn)品詳情
-
Uniprot No.:
-
基因名:
-
別名:Adhesion inhibitory receptor molecule 1 antibody; Adhesion inhibitory receptor molecule 1, siglec 7 antibody; AIRM 1 antibody; AIRM-1 antibody; AIRM1 antibody; CD328 antibody; CD328 antigen antibody; CDw328 antibody; D siglec antibody; D-siglec antibody; HLDA 8 antibody; p75 antibody; p75/AIRM1 antibody; QA79 antibody; QA79 membrane protein antibody; Sialic acid binding Ig like lectin 7 antibody; Sialic acid binding immunoglobulin like lectin 7 antibody; Sialic acid-binding Ig-like lectin 7 antibody; SIGL7_HUMAN antibody; Siglec-7 antibody; SIGLEC19P antibody; SIGLEC7 antibody; SIGLECP2 antibody
-
宿主:Rabbit
-
反應(yīng)種屬:Human
-
免疫原:Synthetic peptide of Human SIGLEC7
-
免疫原種屬:Homo sapiens (Human)
-
標(biāo)記方式:Non-conjugated
-
抗體亞型:IgG
-
純化方式:Antigen affinity purification
-
濃度:It differs from different batches. Please contact us to confirm it.
-
保存緩沖液:-20°C, pH7.4 PBS, 0.05% NaN3, 40% Glycerol
-
產(chǎn)品提供形式:Liquid
-
應(yīng)用范圍:ELISA,WB,IHC
-
推薦稀釋比:
Application Recommended Dilution ELISA 1:2000-1:5000 WB 1:500-1:2000 IHC 1:50-1:200 -
Protocols:
-
儲(chǔ)存條件:Upon receipt, store at -20°C or -80°C. Avoid repeated freeze.
-
貨期:Basically, we can dispatch the products out in 1-3 working days after receiving your orders. Delivery time maybe differs from different purchasing way or location, please kindly consult your local distributors for specific delivery time.
-
用途:For Research Use Only. Not for use in diagnostic or therapeutic procedures.
相關(guān)產(chǎn)品
靶點(diǎn)詳情
-
功能:Putative adhesion molecule that mediates sialic-acid dependent binding to cells. Preferentially binds to alpha-2,3- and alpha-2,6-linked sialic acid. Also binds disialogangliosides (disialogalactosyl globoside, disialyl lactotetraosylceramide and disialyl GalNAc lactotetraoslylceramide). The sialic acid recognition site may be masked by cis interactions with sialic acids on the same cell surface. In the immune response, may act as an inhibitory receptor upon ligand induced tyrosine phosphorylation by recruiting cytoplasmic phosphatase(s) via their SH2 domain(s) that block signal transduction through dephosphorylation of signaling molecules. Mediates inhibition of natural killer cells cytotoxicity. May play a role in hemopoiesis. Inhibits differentiation of CD34+ cell precursors towards myelomonocytic cell lineage and proliferation of leukemic myeloid cells (in vitro).
-
基因功能參考文獻(xiàn):
- Data reported that Siglec-7 was expressed on beta-cells and down-regulated in type 1 and type 2 diabetes and in infiltrating activated immune cells. Furthermore, Siglec-7 seems to play a critical role in the maintenance of an immune-suppressive anti-inflammatory microenvironment, which is lost in diabetes, and may contribute to the manifestation and progression of this metabolic syndrome. PMID: 28378743
- NK cells with Siglec-7neg phenotype possess a high and sustainable killing activity and have the capability to eliminate a NK-resistant leukemia cell and hypersialylated tumor cells PMID: 29617289
- CD56bright NK cells from obese subjects had a reduced expression of Siglec-7 PMID: 28786023
- Siglec-7 defines a highly functional natural killer cell subset and inhibits cell-mediated activities. PMID: 27312286
- Siglec-7 plays a significant role in inhibiting IgE-mediated mast cell activation, but only moderately affects IgE-mediated activation in primary human basophils. PMID: 24810846
- These results show that Siglec-7 binds HIV-1 via gp120 and contributes to enhance the susceptibility to infection of CD4 positive T cells and monocyte-derived macrophages. PMID: 24330394
- Expression of Siglec-7 and -9 ligands was associated with susceptibility of NK cell-sensitive tumor cells and, unexpectedly, of presumably NK cell-resistant tumor cells to NK cell-mediated cytotoxicity. PMID: 24569453
- Based on upregulated SIGLEC7 expression in blood monocytes during relapse, findings suggest a role for SIGLEC7 in acute disease activity in multiple sclerosis. PMID: 22933622
- Siglec-7 participates in generating a monocyte-mediated inflammatory outcome following pathogen recognition. PMID: 23029261
- Regulation of myeloid cell proliferation and survival by p75/AIRM1 and CD33 surface receptors. PMID: 11774609
- high resolution crystal structures of this protein; insights into ligand specificity of this family of proteins PMID: 12438315
- Sialidase unmasking of siglec-7 on NK cells permits it to interact with GD3 on target cells and inhibit killing. This has inplications for tumor escape from NK cells. PMID: 12778482
- x-ray crystallographic analysis of the saccharide-binding domain of p75/AIRM1 PMID: 14747738
- Siglec-7 and Siglec-9 are capable of negative regulation of TCR signaling and ligand binding is required for optimal activity PMID: 15292262
- Siglec-7 can inhibit Fc epsilon receptor I-mediated serotonin release from rat basophilic leukemia cells and recruit the tyrosine phosphatases SHP-1 and SHP-2. PMID: 15557178
- upon pervanadate (PV) treatment, Siglec-7 recruited the protein tyrosine phosphatases Src homology-2 (SH2) domain-containing protein-tyrosine phosphatase-1 and SHP-2 less efficiently than did other inhibitory receptors PMID: 15703304
- structural analysis of siglec-7 in complex with sialosides PMID: 16623661
- Siglecs-7 did not interact with sulfate derivatives of LacNAc and sulfated oligosaccharides containing sialic acid. PMID: 16732727
- The expression levels of Siglec-7 were detectable in bone marrow plasma from AML patients and serum from normal donors. PMID: 16828866
- The species-specific differences in the expression expression of Siglecs in SIV infection was studied. PMID: 18331725
- The decreased expression of Siglec-7 represents an early marker of dysfunctional natural killer-cell subsets associated with high levels of HIV-1 viremia. PMID: 19710502
顯示更多
收起更多
-
亞細(xì)胞定位:Membrane; Single-pass type I membrane protein.
-
蛋白家族:Immunoglobulin superfamily, SIGLEC (sialic acid binding Ig-like lectin) family
-
組織特異性:Predominantly expressed by resting and activated natural killer cells and at lower levels by granulocytes and monocytes. High expression found in placenta, liver, lung, spleen, and peripheral blood leukocytes.
-
數(shù)據(jù)庫(kù)鏈接:
Most popular with customers
-
YWHAB Recombinant Monoclonal Antibody
Applications: ELISA, WB, IHC, IF, FC
Species Reactivity: Human, Mouse, Rat
-
Phospho-YAP1 (S127) Recombinant Monoclonal Antibody
Applications: ELISA, WB, IHC
Species Reactivity: Human
-
-
-
-
-
-